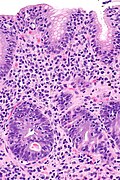
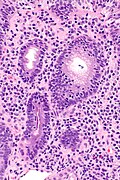

Lymphocytic gastritis
Jump to navigation
Jump to search
| Lymphocytic gastritis | |
|---|---|
| Diagnosis in short | |
 Lymphocytic gastritis. H&E stain. (WC/Nephron) | |
|
| |
| LM | intraepithelial lymphocytes (>25 lymphocytes/100 epithelial cells) |
| Subtypes | primary (idiopathic), secondary |
| LM DDx | Helicobacter gastritis, Crohn's disease, lymphoma |
| Site | stomach |
|
| |
| Associated Dx | celiac disease (common), HIV |
| Clinical history | dependent on underlying cause |
| Prevalence | rare |
| Prognosis | benign |
| Treatment | dependent underlying cause |
Lymphocytic gastritis, abbreviated LG, is a rare form of gastritis, typically associated with celiac disease or Helicobacter pylori infection.
General
The DDx is limited:
- Celiac disease - most common (39 of 82 cases in one series[1]).
- Helicobacter gastritis - common (30 of 82 cases in one series[1]).
- Idiopathic.
- HIV/AIDS.
- Crohn's disease.
- Lymphoma.
Microscopic
Features:[2]
- 25 lymphocytes / 100 epithelial cells.
DDx:
- Helicobacter gastritis - Helicobacter-like organisms present.
- Lymphoma - esp. MALT lymphoma.
Images
IHC
- Lymphocytes CD8 predominant; can be used to help exclude MALT lymphoma.
See also
References
- ↑ 1.0 1.1 Wu, TT.; Hamilton, SR. (Feb 1999). "Lymphocytic gastritis: association with etiology and topology.". Am J Surg Pathol 23 (2): 153-8. PMID 9989841.
- ↑ Feeley, KM.; Heneghan, MA.; Stevens, FM.; McCarthy, CF. (Mar 1998). "Lymphocytic gastritis and coeliac disease: evidence of a positive association.". J Clin Pathol 51 (3): 207-10. PMID 9659261.